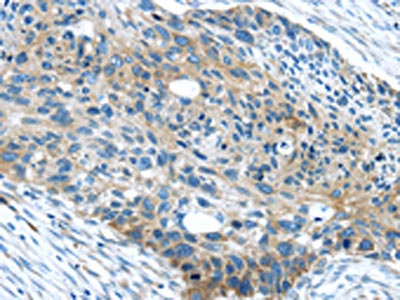

WASF2 Antibody
-
中文名稱:WASF2兔多克隆抗體
-
貨號:CSB-PA442448
-
規格:¥1100
-
圖片:
-
The image on the left is immunohistochemistry of paraffin-embedded Human brain tissue using CSB-PA442448(WASF2 Antibody) at dilution 1/25, on the right is treated with synthetic peptide. (Original magnification: ×200)
-
The image on the left is immunohistochemistry of paraffin-embedded Human esophagus cancer tissue using CSB-PA442448(WASF2 Antibody) at dilution 1/25, on the right is treated with synthetic peptide. (Original magnification: ×200)
-
Gel: 8%SDS-PAGE, Lysate: 40 μg, Lane: Mouse lung tissue, Primary antibody: CSB-PA442448(WASF2 Antibody) at dilution 1/200 dilution, Secondary antibody: Goat anti rabbit IgG at 1/8000 dilution, Exposure time: 1 minute
-
-
其他:
產品詳情
-
Uniprot No.:
-
基因名:
-
別名:DICTYOSTELIUM antibody; dJ393P12.2 antibody; IMD2 antibody; Protein WAVE-2 antibody; Putative Wiskott Aldrich syndrome protein family member 4 antibody; SCAR 2 antibody; SCAR antibody; SCAR2 antibody; Suppressor of cyclic-AMP receptor (WASP family) antibody; Verprolin homology domain-containing protein 2 antibody; WASF2 antibody; WASF2_HUMAN antibody; WASF4 antibody; WASP family protein member 2 antibody; WASP family protein member 4 antibody; WASP family Verprolin homologous protein 2 antibody; WASP-family protein member 2 antibody; WAVE 2 antibody; WAVE2 antibody; Wiskott-Aldrich syndrome protein family member 2 antibody; Wiskott-Aldrich syndrome protein family verprolin-homologous protein antibody
-
宿主:Rabbit
-
反應種屬:Human,Mouse
-
免疫原:Synthetic peptide of Human WASF2
-
免疫原種屬:Homo sapiens (Human)
-
標記方式:Non-conjugated
-
抗體亞型:IgG
-
純化方式:Antigen affinity purification
-
濃度:It differs from different batches. Please contact us to confirm it.
-
保存緩沖液:-20°C, pH7.4 PBS, 0.05% NaN3, 40% Glycerol
-
產品提供形式:Liquid
-
應用范圍:ELISA,WB,IHC
-
推薦稀釋比:
Application Recommended Dilution ELISA 1:1000-1:2000 WB 1:200-1:1000 IHC 1:25-1:100 -
Protocols:
-
儲存條件:Upon receipt, store at -20°C or -80°C. Avoid repeated freeze.
-
貨期:Basically, we can dispatch the products out in 1-3 working days after receiving your orders. Delivery time maybe differs from different purchasing way or location, please kindly consult your local distributors for specific delivery time.
-
用途:For Research Use Only. Not for use in diagnostic or therapeutic procedures.
相關產品
靶點詳情
-
功能:Downstream effector molecule involved in the transmission of signals from tyrosine kinase receptors and small GTPases to the actin cytoskeleton. Promotes formation of actin filaments. Part of the WAVE complex that regulates lamellipodia formation. The WAVE complex regulates actin filament reorganization via its interaction with the Arp2/3 complex.
-
基因功能參考文獻:
- Results show that in cisplatin-resistant cervical cancer tissues, Rac1, and Wave2 mRNA expression was significantly up-regulated compared to that of the cisplatin-sensitive cervical cancer tissues. In HeLa and Caski cervical cancer cell lines, Rac1 activity and Wave2 protein expression was significantly promoted by SH3BP1 overexpression. PMID: 28786507
- Studied leucine rich repeat kinase 2 (LRRK2)-WAS protein family member 2 (WAVE2) pathway in modulation of phagocytosis in leukocytes, as well as its possible role for altered immune function in Parkinson's Disease. PMID: 29760073
- The level of WASF2 in gastric cancer tissues was negatively correlated with miR-146a expression and had inverse clinicopathologic features. The newly identified miR-146a/WASF2 axis may provide a novel therapeutic target for gastric cancer. PMID: 28387985
- SH3BP1 promoted VEGF secretion via Rac1-WAVE2 signaling, so as to exert an augmentation on cell invasion and microvessel formation. PMID: 26933917
- the MCP1-induced cortactin phosphorylation is dependent on PLCb3-mediated PKC activation, and siRNA-mediated down-regulation of either of these molecules prevents cortactin interaction with WAVE2 PMID: 26490115
- WASp and WAVE2 differ in their dynamics and their associated proteins PMID: 25342748
- Decreased expression of Wiskott-Aldrich syndrome protein family verprolin-homologous protein 2 may be involved in the development of pre-eclampsia. PMID: 24125947
- these results suggest that Arp2/3 and the upstream regulator, WAVE2, are essential co-factors hijacked by HIV for intracellular migration, and may serve as novel targets to prevent HIV transmission. PMID: 24415754
- WAVE2 is down-regulated in gastric cancer PMID: 24778020
- data reveal a critical role for WAVE2 complex in regulation of cellular signaling and epithelial morphogenesis PMID: 23691243
- Identification of an onco-suppressive role of miR-146a in gastric cancer cells by its reduction of WASF2 expression. PMID: 23435376
- results suggest that SKAP2 negatively regulates cell migration and tumor invasion in fibroblasts and glioblastoma cells by suppressing actin assembly induced by the WAVE2-cortactin complex PMID: 23161539
- results indicate that by mediating intensive F-actin accumulation at the sites of cell infiltration, WAVE2, N-WASP, and Mena are crucial for PI3K-dependent cell invasion induced by PDGF PMID: 21769917
- WAVE2 and WASp define parallel pathways to F-actin reorganization and function in NK cells; although WAVE2 was not required for NK cell innate function, it was accessible through adaptive immunity via IL-2. PMID: 21383498
- Data suggest that ERK coordinates adhesion disassembly with WAVE2 regulatory complex activation and actin polymerization to promote productive leading edge advancement during cell migration. PMID: 21419341
- WAVE2 works as an A-kinase-anchoring protein that recruits PKA at membrane protrusions and plays a role in the enlargement of membrane protrusions induced by PKA activation PMID: 21119216
- MYH9 is required for lamellipodia formation since it provides contractile forces and tension for the F-actin network to form convex arcs at the leading edge through constitutive binding to WAVE2 and colocalization with PIP(3) in response to IGF-I. PMID: 21184743
- WAVE2 complexs with insulin receptor substrate p53 and is crucial for membrane targeting followed by local accumulation of WAVE2 at the leading edge of cells. PMID: 20621182
- WAVE2-membrane targeting is directionally controlled by binding of the EB1-stathmin complex to WAVE2-bearing microtubules and by the interaction between WAVE2 and PIP3 produced near IGF-IR that is locally activated by IGF-I. PMID: 19925864
- The WAVE2-Abi1-Nap1-PIR121 complex is as active as the WAVE2-Abi1 sub-complex in stimulating Arp2/3, and after Rac activation it is re-localized to the leading edge of ruffles in vivo. PMID: 15048123
- reconstitution of the Wave-2 complex and a study of the molecular architecture PMID: 15070726
- Results suggest that phosphatidylinositol (3,4,5)-triphosphate recruits WAVE2 to the polarized membrane and that this recruitment is essential for lamellipodium formation at the leading edge. PMID: 15107862
- the 3 WAVE isoforms exhibit common and distinct features and may potentially be involved in the regulation of actin cytoskeleton in platelets PMID: 15280206
- WAVE-2 and WAVE-3 expression was not changed by the megakaryocytic differentiation; WAVE-1 and WAVE-2 moved from a detergent-soluble cytosolic fraction to insoluble cytoskeleton fraction after platelet aggregation PMID: 15670045
- WAVE2 is a key component of the actin regulatory machinery in T cells and that it also participates in linking intracellular calcium store depletion to calcium release-activated calcium (CRAC) channel activation. PMID: 16401421
- Therefore, IRSp53 optimizes the activity of the WAVE2 complex in the presence of activated Rac and PIP(3). PMID: 16702231
- WAVE2 expression is elevated in HCC tissues, which correlates with a poor prognosis, suggesting WAVE2 as a candidate prognostic marker of HCC. PMID: 17020969
- Colocalization of Arp2 and WAVE2 is an independent risk factor for liver metastasis of colorectal carcinoma. PMID: 17459058
- Results decribe a mechanism in which signals from the T cell receptor produce WAVE2-ARP2/3-mediated de novo actin polymerization, leading to integrin clustering and high-affinity binding through the recruitment of vinculin and talin. PMID: 17591693
- Over-expression of WAVE2 is seen in node-positive cases as well as in moderately and poorly differentiated breast cancers. PMID: 18509249
- Data suggest that the promotion of lamellipodia formation by HGF in MDA-MB-231 cells is Rac1-dependent and requires KIF5B-mediated transport of WAVE2 and IQGAP1 to the cell periphery along microtubules. PMID: 18514191
- results suggest that long protrusions formed in a WAVE2- and microtubule-dependent manner may identify the cells at the later stage of invasion, possibly after the formation of invadopodia in the 3-D cultures PMID: 18795939
- Results identify a mechanism by which the WAVE2 complex regulates T cell receptor signaling to Rap1 and integrin activation via Abl- and CrkL-C3G. PMID: 18809728
- Phosphorylation of all five sites on endogenous WAVE2 and their mutation to non-phosphorylatable alanine residues leads to inhibition of WAVE2 function in vivo, was demonstrated. PMID: 19012317
- Pak1 protein binds to WASF2 protein and is transported with WASF2 protein to the leading edge by stimulation with hepatocyte growth factor. PMID: 19162178
- betaPIX and GIT1 regulate the hepatocyte growth factor-induced and Rac1-dependent membrane transport of WAVE2 and consequently, lamellipodia formation. PMID: 19303398
- HSPC300 is associated with metastatic potential of lung squamous cell carcinoma through its interaction with WAVE2 PMID: 19576655
- Data show that activation of the WAVE2 complex requires simultaneous interactions with prenylated Rac-GTP and acidic phospholipids, as well as a specific state of phosphorylation. PMID: 19917258
顯示更多
收起更多
-
亞細胞定位:Cytoplasm, cytoskeleton. Cell projection, lamellipodium. Basolateral cell membrane.
-
蛋白家族:SCAR/WAVE family
-
組織特異性:Expressed in all tissues with strongest expression in placenta, lung, and peripheral blood leukocytes, but not in skeletal muscle.
-
數據庫鏈接:
Most popular with customers
-
-
YWHAB Recombinant Monoclonal Antibody
Applications: ELISA, WB, IHC, IF, FC
Species Reactivity: Human, Mouse, Rat
-
Phospho-YAP1 (S127) Recombinant Monoclonal Antibody
Applications: ELISA, WB, IHC
Species Reactivity: Human
-
-
-
-
-